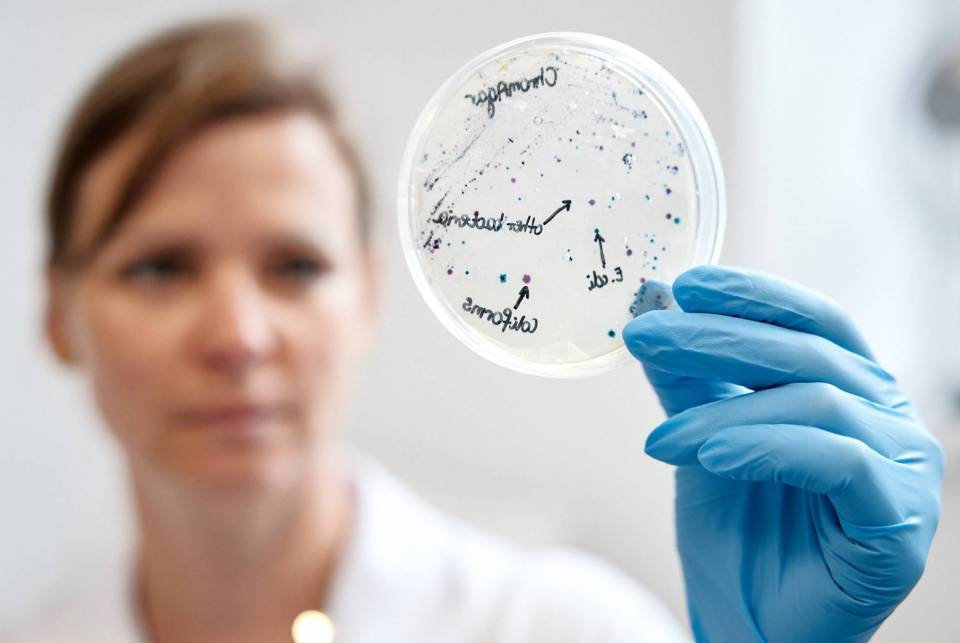
prot8

Najważniejsze wideo w ela24

Funduszowy Maj – cykl darmowych wydarzeń organizowanych w całym województwie łódzkim
Liczba osób, które zobaczyły to wideo78 241 wyświetlenia
Dożynki Województwa Łódzkiego 2025
Liczba osób, które zobaczyły to wideo698 259 wyświetlenia
Takiego wideo jeszcze nie widzieliście. Obejrzyjcie do końca
Liczba osób, które zobaczyły to wideo388 582 wyświetlenia
Mistrzostwa w sporcie pożarniczym w Grabowie
Liczba osób, które zobaczyły to wideo384 808 wyświetlenia
Pożar gazociągu w Gałkowie Dużym
Liczba osób, które zobaczyły to wideo378 237 wyświetlenia
W Bratoszewicach odbyły się kolejne Targi Rolne “Agrotechnika”
Liczba osób, które zobaczyły to wideo403 438 wyświetlenia
Poważny wypadek w gminie Zelów
Liczba osób, które zobaczyły to wideo74 850 wyświetlenia
Sławomir Mentzen spotkał się z mieszkańcami regionu
Liczba osób, które zobaczyły to wideo160 661 wyświetlenia
Duża akcja policji w Łódzkiem. Zatrzymano blisko 100 przestępców!
Liczba osób, które zobaczyły to wideo456 541 wyświetlenia
Przywiózł ładunek wybuchowy i zostawił go pod nocnym klubem
Liczba osób, które zobaczyły to wideo114 492 wyświetlenia
"Adwentowy kalendarz życzliwości i pozytywnego myślenia"
Liczba osób, które zobaczyły to wideo382 336 wyświetlenia
W Zgierzu odbyła się gala sportów walki federacji Gunners Fight Night
Liczba osób, które zobaczyły to wideo198 610 wyświetlenia
Wielki sukces polskich strażaków w Holandii! Zdobyli złoto i brąz Mistrzostw Świata
Liczba osób, które zobaczyły to wideo374 012 wyświetlenia![Lekarze ze szpitala w Sieradzu wycięli pacjentowi 52-centymetrowy guz [DRASTYCZNE NAGRANIE]](/components/com_allvideoshare/assets/images/play.png)
Lekarze ze szpitala w Sieradzu wycięli pacjentowi 52-centymetrowy guz [DRASTYCZNE NAGRANIE]
Liczba osób, które zobaczyły to wideo325 365 wyświetlenia
Niezwykłe znaleziska podczas przebudowy ulic. Wszystkie przedmioty trafiły do...
Liczba osób, które zobaczyły to wideo400 201 wyświetlenia
W Tumie wręczono kolejne Nagrody im. Benedykta Polaka
Liczba osób, które zobaczyły to wideo329 322 wyświetlenia
Zapraszamy na Dożynki Powiatu Poddębickiego
Liczba osób, które zobaczyły to wideo108 477 wyświetlenia
Dożynki Gminy Daszyna
Liczba osób, które zobaczyły to wideo520 219 wyświetlenia
Województwo Łódzkie - rusza nowy program dla osób, które cierpią na bóle i choroby kręgosłupa, pleców oraz stawów
Liczba osób, które zobaczyły to wideo378 360 wyświetlenia
Dożynki Wojewódzkie 2024 w Spale
Liczba osób, które zobaczyły to wideo513 453 wyświetlenia
Potężny pożar zakładu w Żłobnicy
Liczba osób, które zobaczyły to wideo145 072 wyświetlenia
Bełchatów gospodarzem mistrzostw świata w nordic walking! Na trasy wyjdzie ponad 800 zawodników z 21 krajów
Liczba osób, które zobaczyły to wideo315 791 wyświetlenia
Poznaj Pana Bogusława z RGE "Żyj zdrowo"
Liczba osób, które zobaczyły to wideo315 936 wyświetlenia